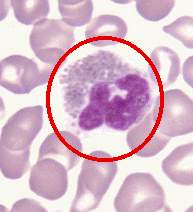
嗜酸性

介紹
嗜酸性
嗜酸性相關知識
嗜酸性粒細胞描述:細胞質內含深紅色大型顆粒。細胞核的形狀與嗜中性白細胞相似,通常有2-3葉,約占白細胞總數的4%。
血液中嗜酸性粒細胞占白細胞總數的2%-4%,即100-350個細胞/μ1。血液中嗜酸性粒細胞的數目有明顯的晝夜周期性波動,清晨細胞數減少,午夜時細胞數增多。這種細胞數的周期性變化是與腎上腺皮質釋放糖皮質激素量的晝夜波動有關的。當血液中皮質激素濃度增高時,嗜酸性粒細胞數減少;而當皮質激素濃度降低時,細胞數增加。嗜酸性粒細胞的胞質內含有較大的、橢圓形的嗜酸性顆粒。這類白細胞也具有吞噬功能。

